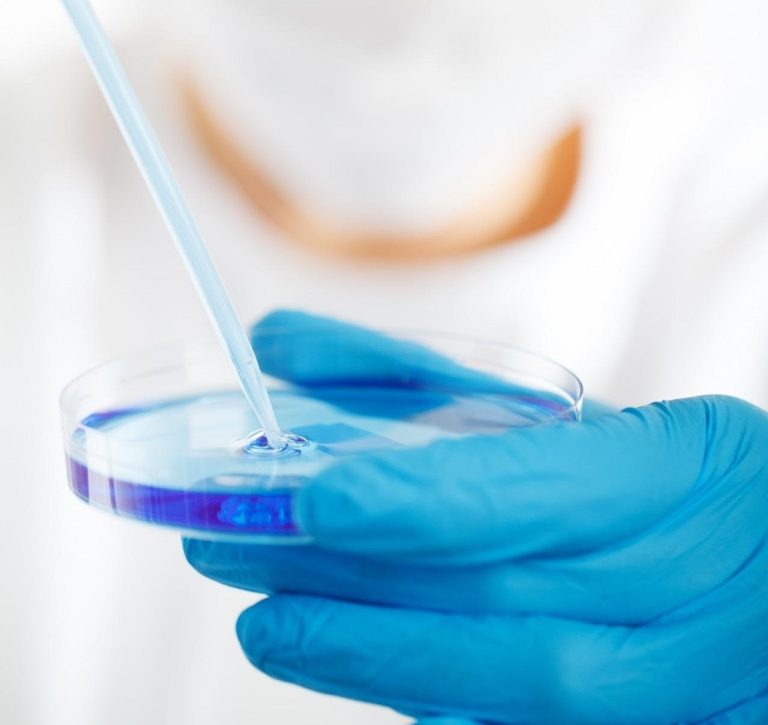
Petriho miska vedec výskum laboratórium

NAŽIVO
Steinmeier vyzval USA, aby v rámci NATO zostali spoľahlivou silou. Predtým Trump vyhlásil, že USA znížia počet vojakov umiestnených v Nemecku o výrazne viac ako 5000.
Rodiny detí s autizmom a neurovývinovými poruchami čelia po zavedení integrovaných posudkov výraznému poklesu sociálnej podpory a existenčnej kríze. Upozornilo na to opozičné KDH, podľa ktorého súčasná prax integrovaných posudkov spôsobuje v mnohých prípadoch prehliadanie reálnych potrieb ľudí so zdravotným znevýhodnením. Ministra práce Erika Tomáša (Hlas-SD) vyzvali, aby situáciu riešil. Rezort práce apeluje na opozičných poslancov, aby rodiny nestrašili.
Čítať viac | 15:08Ministerstvo zdravotníctva Libanonu uviedlo, že útok Izraela v údolí Bikáa si vyžiadal štyri obete.
15:01Zhoršenie ratingu Slovenskej republiky agentúrou Standard and Poor’s (S&P) vníma bývalý premiér a exminister financií Eduard Heger z mimoparlamentnej strany Demokrati ako dôležitý negatívny ekonomický signál a jeho zľahčovanie zo strany vlády považuje za nevhodné. Konštatoval to v TASR TV.
Čítať viac | 14:50Trump v stredu pohrozil Iránu obnovením útokov, ak nepristúpi na dohodu s USA.
14:47Rožňavskí hasiči zasahujú pri dopravnej nehode nákladného vozidla, ku ktorej došlo na ceste v katastri obce Kováčová v okrese Rožňava. Ako uviedlo Krajské riaditeľstvo Hasičského a záchranného zboru (HaZZ) v Košiciach na sociálnej sieti, vodič zostal zakliesnený v kabíne.
Čítať viac | 14:37Policajná hovorkyňa v Úsťanskom kraji Eliška Kubíčková uviedla, že polícia preveruje, či pri požiari v Národnom parku České Švajčiarsko nemohlo ísť aj o úmysel.
14:35Ukrajinský prezident Volodymyr Zelenskyj v stredu obvinil Rusko, že odmietlo snahy o zastavenie bojov a pokračuje v útokoch napriek návrhu jednostranného prímeria zo strany Kyjeva. Vyjadrenia zazneli len niekoľko dní pred ruskými oslavami Dňa víťazstva 9. mája, ktoré sprevádzajú obavy z možných ukrajinských útokov na Moskvu.
Čítať viac | 14:30Pápež navštívi v júni dva Kanárske ostrovy, ktoré sú hlavnými vstupnými bodmi pre migrantov.
14:29USA očakávajú, že nový iracký premiér urobí kroky na oddelenie štátu od proiránskych skupín.
14:23V noci zo stredy na štvrtok (7. 5.) sa na Mohyle Milana Rastislava Štefánika na vrchu Bradlo v okrese Myjava uskutoční slávnostný ceremoniál odovzdania funkcie náčelníka Generálneho štábu (GŠ) Ozbrojených síl (OS) SR. Informovala o tom trenčianska krajská polícia a mesto Brezová pod Bradlom.
Čítať viac | 14:18Svetové zásoby ropných produktov, ako sú benzín, nafta a letecké palivo, vystačia už len na 45 dní, informuje Financial Times s odvolaním sa na údaje spoločnosti Goldman Sachs.
K mimoriadne výraznému poklesu zásob dochádza najmä v Ázii a Afrike.
14:12Situácia na výletnej lodi MV Hondius, ktorá sa ocitla v centre medzinárodného zdravotného incidentu, sa ďalej vyvíja a komplikuje. Výskyt hantavírusu na palube vyvolal evakuácie, medzinárodné trasovanie kontaktov a zásah odborníkov aj zo strany Svetovej zdravotníckej organizácie (WHO).
Čítať viac | 14:08Wladyslaw Kosiniak-Kamysz povedal, že kvôli vyššej bezpečnosti a kvalite života sa mladí ľudia zo západnej Európy budú chcieť sťahovať do Poľska a ďalších krajín strednej Európy.
14:05Na pozadí špekulácií o dosiahnutých dohodách medzi USA a Iránom začali klesať ceny ropy.
Cena ropy Brent klesla pod hranicu 100 dolárov za barel.
Oficiálne však nebol potvrdený žiadny pokrok v rokovaniach.
13:58Ministerstvo školstva, výskumu, vývoja a mládeže (MŠVVaM) SR podpísalo memorandum o spolupráci so spoločnosťou Google, ktorá pomôže posunúť využívanie umelej inteligencie (AI) v školách do ďalšej fázy. Učitelia by mali podľa plánu do konca roka 2026 získať prístup k moderným AI nástrojom, školy nové technologické riešenia a vzdelávací systém podporu rozvoja digitálnych zručností.
Čítať viac | 13:48Niekoľko ministrov, bývalých diplomatov a predstaviteľov štátov vyzvali EÚ, aby konala proti nelegálnym izraelským osadám na okupovanom Západnom brehu Jordánu.
13:47Pakistanský premiér Šahbáz Šaríf, ktorý vystupuje ako jeden z hlavných sprostredkovateľov v mierovom úsilí o ukončenie vojny medzi Iránom a Spojenými štátmi a Izraelom, v stredu vyhlásil, že je „optimistický“, pokiaľ ide o aktuálnu dynamiku rokovaní, ktorá by mohla priniesť mier na Blízkom východe.
Čítať viac | 13:42Európsky fyzický trh s ropou sa napriek pokračujúcej dvojnásobnej blokáde Hormuzského prielivu relatívne upokojil. Podľa analytika J&T Stanislava Pánisa by v základnom scenári nemal nastať fyzický nedostatok leteckého paliva, ceny však zostávajú výrazne vyššie ako pred vypuknutím vojny na Blízkom východe.
Čítať viac | 13:37Polícia vyšetruje dopravnú nehodu, ktorá sa stala 27. apríla popoludní od obce Ivanka pri Dunaji smerom na Svätý Jur. Došlo pri nej k zrážke cyklistu a motocyklistu, pričom cyklista zraneniam podľahol. Informuje o tom polícia na sociálnej sieti
Čítať viac | 13:31Polícia vyšetruje požiar v obci Huncovce, okres Kežmarok, ku ktorému došlo v pondelok (4. 5.) podvečer v areáli jednej z firiem. Krajská policajná hovorkyňa z Prešova Jana Ligdayová informovala, že vyšetrovateľ Okresného riaditeľstva Policajného zboru v Kežmarku vedie v prípade trestné stíhanie pre trestný čin všeobecného ohrozenia. Oheň spôsobil vysoké škody.
13:19OSN žiada Izrael o prepustenie aktivistov z lode smerujúcej do Gazy. OHCHR vyzýva Izrael, aby prestal využívať svojvoľné zadržiavanie.
13:09Európska prokuratúra začala stíhanie vo veci agrodotácií v Chorvátsku. Vyšetrovanie sa týka činnosti niekoľkých Chorvátov, ktorých podozrievajú zo zneužitia úradnej moci a právomoci, prijímania a ponúkania úplatkov, subvenčného podvodu a falšovania
13:08Magyara vo štvrtok prijme talianska premiérka Meloniová. Stretnutie, ktoré sa podľa plánu uskutoční o 10.00 h SELČ v sídle talianskej premiérky v paláci Chigi, potvrdila aj jej kancelária na svojej webovej stránke.
12:34Z trestného činu ohrozenia pod vplyvom návykovej látky polícia obvinila 48-ročnú Prešovčanku. TASR o tom informovala hovorkyňa Krajského riaditeľstva Policajného zboru v Prešove Jana Ligdayová.
Ako uviedla, žena v utorok (5. 5.) večer na Višňovej ulici v Prešove viedla osobné motorové vozidlo. Z dôvodu, že počas jazdy prekročila maximálnu povolenú rýchlosť v obci, vozidlo zastavila policajná hliadka a vodičku podrobila kontrole.
„Výsledok dychovej skúšky u 48-ročnej Prešovčanky presiahol dve promile. Žena skončila v cele policajného zaistenia,“ uviedla Ligdayová.